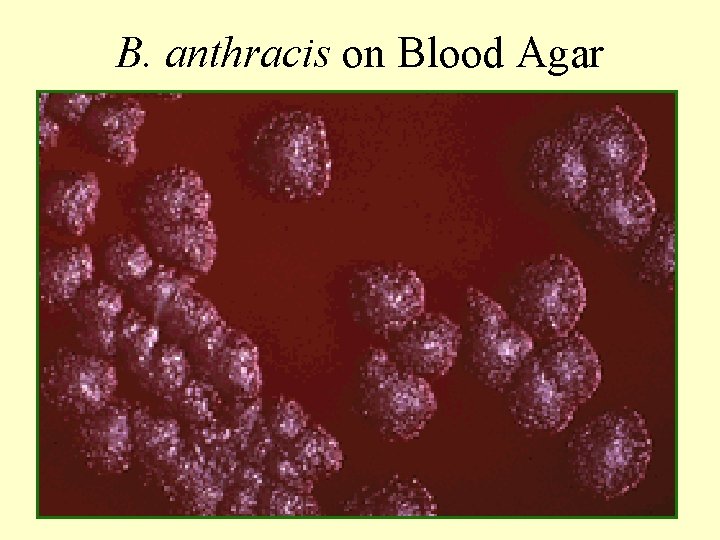
B. anthracis on Blood Agar

ANTHRAX Humberto Guerra Instituto de Medicina Tropical Alexander

ANTHRAX Humberto Guerra Instituto de Medicina Tropical Alexander von Humboldt UNIVERSIDAD PERUANA CAYETANO HEREDIA

ANTHRAX • • • - Etiologic agent: Bacillus anthracis Cohn 1875. - Large (8 x 1. 2 mm) Gram positive, nonmotile, weakly hæmolytic; central spores, straight ends, encapsulated in vivo, produces long chains. - Pathogenic to herbivores, man, lab animals. - Habitat: Parasitic; persists in “cursed” fields. - Sporulation only in aerobic conditions. - Capsule antigen: poly D-glutamic acid g-peptide - Immunogenic protein toxin, edematizing, lethal.

Bacillus anthracis: culture

(blue) (red)
B. anthracis on Blood Agar

Bacillus anthracis in a lesion

Inflammatory cells Bacilli

Lymph node: necrosis, large bacilli

STAGES OF INFECTION • Encounter: organism and body surfaces • Adhesion: generalized and receptor-specific • Initial multiplication in situ colonization • Invasion breaching of anatomic barriers • Lymphatic stage invasion of bloodstream • Generalized infection, metastases local colonizations, “tropisms” of certain organisms.

Natural history of Anthrax • Encounter: defines disease type and outcome: • Herbivores: Spores germinate, are eaten, and oral lesions or abrasions mediate blood invasion • Man: Spores in wool, hair, hide skin or lung Vegetative forms in meat bowel lesions • Adhesion: spores or vegetative forms stick to tissues and multiply until they breach anatomic barriers: • Invasion: first local, then lymphatic, and later • Generalized infection leading to death.

Malignant pustule • Anthrax proper, Charbon • In endemic areas, through contact with infected animals • In industry, contact with hides, bones, wool, hair • Occasionally, brushes, bone, ivory, clothes, etc. • History in days: incubation of 3 to 4 days; then, – 1) Initial pimple or papule, single or multiple – 2) Vesicle ring around papule - initially, clear fluid – 3) Papule ulcerates, dries, becomes dark eschar – 3) Edema develops, becomes angry red – 3 -on) No local pain, but local ganglia grow tender – 4) Eschar blackens, grows on vesicles, thickens

Ulcer and vesicle ring

Black eschar. Redness remains

Site of Malignant pustule • Head: usually no complication • Face: severe, superinfection; gangrene near eye • Neck, breast or chest wall: massive edema, over thorax and sometimes involving scrotum • Shoulders, arms: may be multiple, small lesions • Forearms, fingers: atypical on palms • General symptoms, fever, chills, depend on site. • Weakness, hypotension are danger signs.

Notice the edema and typical lesions

Very localized thumb lesion. Tough subcutaneous tissues limit the lesion



Notice small finger ulcer, but large edema and erythema

The forehead lesion is minimal. This could be due to the localization or to a previous state of immunity

Taken from the AFIP Atlas

Pulmonary Anthrax • • Aspiration anthrax - Requires high inoculum - Man resists over 2, 000 inhaled spores/day. Onset abrupt - The patient is acutely ill in hours: fever, dyspnea, cyanosis, rales, tachycardia, feeble pulse, hypotension. Vomiting, sweating, anxiety. Death in 2 or 3 days if untreated. Lesions in mediastinal lymph nodes, carried there by alveolar macrophages, causing edema, toxemia, bacteremia.

Woolsorter’s Disease (AFIP)

THE SVERDLOVSK ANTHRAX OUTBREAK • An outbreak of anthrax occurred during April, 1979, among people who lived or worked in a narrow zone downwind of a Soviet military microbiology facility in Sverdlovsk (now Ekaterinburg) Russia. In addition, livestock died of anthrax within a larger downwind zone. The facility was suspected by western intelligence of being a biological warfare research facility. Intelligence analysts attributed the outbreak to the accidental airborne release of anthrax spores. The Soviets maintained that the outbreak was de to ingestión of contaminated meat purchased on the black market. Finally, in 1992, President Yeltsin of Russia admitted that the facility had been part of an offensive biological weapons program, and that the disease in animals and people resulted from an accidental release of anthrax spores.

Gastric and Intestinal Anthrax • Acute gastro-enteritis, abdominal pain, prostration. • Often fatal. • Intestinal lesions edematous, with black eschar • obstruction, enlarged, hemorrhagic mesenteric lymph nodes.

Cecal Lesion from eating undercooked Carabao. . . (AFIP)

Anthrax Meningitis • Usually a complication of anthrax septicemia. • Subarachnoid haemorrhage is a common feature • Very often fatal

Anthrax meningitis: Subarachnoid Haemorrhage (AFIP)

Anthrax - Disease in animals • • Fulminating, acute, subacute or chronic. Apoplectic death: “fall” - animals found dead. Acute: excitable, then depressed, cardiac and respiratory distress, trembling, staggering, convulsions. • Edematous lesions, blood exudes, incoagulable. • Death in 1 -2 days, or 4 -5. • Chronic infection in more resistant animals: pigs.

The inoculated mouse is jumpy, its hair is raised, its tail stiff , and has an unsure gait

There’s fluid in the peritoneal cavity: ascitis

Organs are edematous, spleen is black and congested

Prevention • Control in animals. Annual vaccination protects. • Disposal of animal carcasses: disinfect with oil, burn, bury deep, covered with quicklime. • Spores will NOT form inside the carcass, and putrefaction kills the Bacillus. Flies feeding on incoagulable blood may be a problem.

Global Health Network Epidemiology Supercourse: Zoonoses

An anthrax site near the road. Notice the epidemiology team, recently obtained skin

A more remote anthrax site (2 slides)

A typical cowgirl. Notice building materials, number of different animals

Global Health Network Epidemiology Supercourse: Zoonoses



Prevention • Control in animals. Annual vaccination protects. • Disposal of animal carcasses: disinfect with oil, burn, bury deep, covered with quicklime. • Spores will NOT form inside the carcass, and putrefaction kills the Bacillus. Flies feeding on incoagulable blood may be a problem.

Veterinary Dr. vaccinating in an anthrax site

An anthrax death. Notice flies feeding on blood and secretions

A community asset: empiric “vet” couple. Notice vaccine ampule on chair

Burning a carcass in a hole. . . Not deep enough


Prevention • Industrial protection. Gloves, masks, disinfection of materials prior to handling. Mostly impractical! • Information, charts, education for awareness. • Reporting of sudden illness in risk areas, lesions.

Diagnosis • High suspicion level - Inquire on dead or sick cattle • Examine papules/lesions: scrape, prepare Gram stain, culture. • If needed, blood culture or CNS culture.

Treatment • Penicillin continues to be the treatment of choice. • iv treatment was adopted to provide enough. • Do not incise lesions. • Eschar is not dangerous after treatment. • The patient must remain hospitalized until fully cured.

BIOTERRORISM How real is it? Well, there WERE some bacteria prepared for biological warfare. . . Anthrax was a “first choice”!


EMERGING INFECTIOUS DISEASES Vol 4 No 5 July-August 1999 • Special Issue • The Threat of Biological Attack: Why Concern Now? • David W. Siegrist Potomac Institute for Policy Studies, Arlington, Virginia, USA • For a biological attack to occur, three elements must be in place: a vulnerable target, a person or group with the capability to attack, and the intent (by the perpetrator) to carry out such an attack.


Category A Biological Weapons (Recommendations of the CDC Strategic Planning Workgroup, MMWR, April 21, 2000 / 49(RR 04); 1 -14) • High-priority agents include organisms that pose a risk to national security because they : · can be easily disseminated or transmitted person-to-person; · cause high mortality, with potential for major public health impact; · might cause public panic and social disruption; and · require special action for public health preparedness

Category A agents include • Variola major (smallpox); • Bacteria: Bacillus anthracis (anthrax); Yersinia pestis (plague); Clostridium botulinum toxin (botulism); Francisella tularensis (tularaemia); • Filoviruses: Ebola hemorrhagic fever, Marburg hemorrhagic fever; and • Arenaviruses: Lassa (Lassa fever), Junín (Argentine hemorrhagic fever) and related viruses.

EMERGING INFECTIOUS DISEASES ARTICLE (CONTINUING) The United States is unprepared to deal with a biological attack. (other nations also) Over the past several years, preparedness strides have been made, especially in the largest cities. However, much of the needed equipment is not available. Pathogen sensors are not in place to detect that a biological attack has taken place. New medicines are needed.

In combating terrorist attacks, treatment is a more practical approach than prevention; yet many biological agents are extremely difficult to treat with existing medicines once the symptoms appear. In addition, many of the most important prophylactic drugs have limited shelf lives and cannot be stockpiled. Moreover, their effectiveness could be compromised by a sophisticated attacker.

SOOOOO. . . . It’s clear a vaccine for human use (BOTH FOR MILITARY AND CIVILIAN PERSONNEL) needed. . . is

• The Schedule (for the U. S. A. Armed Forces) · May 18, 1998: Secretary of Defense William Cohen approved the vaccination plan based on the successful completion of all testing and operational criteria · Between now and about 2005, the entire force, including all new service member will begin receiving the six-shot series of the anthrax vaccination in a phased immunization program

The first three shots are given in twoweek intervals. The following three shots are administered at 6, 12, and 18 months. The program also includes an annual booster
- Slides: 60